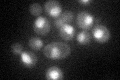
YGR030C
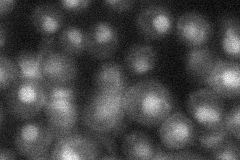
YGR030C
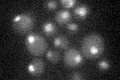
YGR030C

View description
Subunit of both RNase MRP, which cleaves pre-rRNA, and nuclear RNase P, which cleaves tRNA precursors to generate mature 5' ends
Localization:
Intensity:
Fold change:
Significance:
-
C’ GFP library in SD
nucleus41.01 -
N' NOP1pr-GFP in SD

nucleus40.4085 -
N' TEF2pr-mCherry in SD

nucleus63.7919 -
N' NATIVEpr-GFP in SD
nucleus28.6347 -
N' TEF2pr-VC and Cyto-VN in SD

nucleus36.9795 -
C’ GFP library in SD+DTT

nucleus27.530.67No -
C’ GFP library in SD+H2O2

nucleus32.10.78No -
C’ GFP library in Starvation Media
nucleus20.170.49Yes -
C’ GFP library on the background of Pup2-DaMP

nucleus -
C’ GFP library on the background of CCT mutant

nucleus37.50910.914558No
